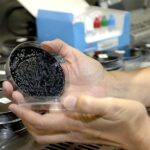

Moradores del biocorredor se reúnen para dar seguridad en la zona.
La lejanía y la falta de iluminación son dos condiciones de la vía Barabón – Sústag – Soldados, al margen del río Yanuncay, en la parroquia San Joaquín, en donde por varias ocasiones se han encontrado cadáveres abandonados.
El más reciente caso de estos ocurrió el pasado viernes 26 de agosto, cuando cerca de las 18:00, ciudadanos que realizaban labores de pesca encontraron un cuerpo decapitado entre unas rocas en medio del río, en el sector de San José de Barabón.
La víctima fue identificada como Jonathan Ordóñez, de 29 años. Era oriundo del cantón Santa Rosa, provincia del El Oro. Las autoridades explicaron que el ciudadano salió hace pocos días de la cárcel de Machala por un delito de asesinato, por lo que presumen de un posible ajuste de cuentas.
Hasta la fecha aún no ha sido localizada la cabeza. El Grupo de Operaciones Especiales (GOE), de la Policía Nacional, continúa con la búsqueda. Este crimen ha provocado temor y preocupación en los moradores del biocorredor Soldados-Yanuncay.

Moradores
William Otavalo, representante de los restaurantes del lugar, informó que han hecho reuniones con los moradores y la Policía del circuito San Joaquín para coordinar acciones para evitar que esta zona se convierta en un depósito de cadáveres.
Agregó que alrededor de unas 30 personas conformaron brigadas para patrullar con la Policía en horarios estratégicos. Dijo que instalarán cámaras de videovigilancia.
Advirtió que harán justicia por mano propia si encuentran a antisociales cometiendo algún delito. Recordó que en 2013 una mujer, de 25 años, fue quemada y abandonada maniatada en la orilla del río Yanuncay.
Más muertes
En mayo del 2022 un joven de 24 años fue hallado muerto con un disparo en la cabeza junto al río Yanuncay, en el sector de Soldados Chico. También en julio de 2016 fue encontrado el cadáver de la adolescente Estefanía Muñoz, embalado, en el río Yanuncay. Este crimen no ha sido resuelto. (IVM)-(I)